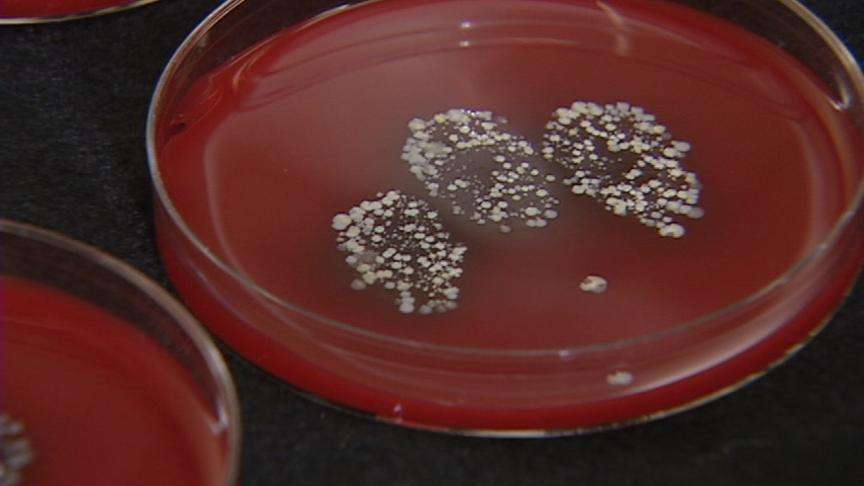
Hand sanitizers: clean hands or a false sense of security?

Estimated read time: 3-4 minutes
This archived news story is available only for your personal, non-commercial use. Information in the story may be outdated or superseded by additional information. Reading or replaying the story in its archived form does not constitute a republication of the story.
Debbie Dujanovic reporting
Produced by Kelly Just They seem like a stroke of genius: A way to clean your hands anywhere, no water required. In no time at all, hand sanitizers became part of our daily lives. The Salt Lake Police Department makes sure officers have them handy. Local schools stock it to keep children healthy. And a single bottle can cost you as much as $4.
The Centers for Disease Control (CDC) says they can keep us healthier by getting rid of the common germs that cause tummy troubles and infections. Many even promise to kill nearly 100 percent of germs. But do they always work as advertised? Could these products be giving you a false sense of security?
We randomly purchased 10 brands of hand sanitizers and took them to Data Chem laboratories in Murray to test them out. We requested the lab run a single test on each hand sanitizer. Who better to put the sanitizers to the test than a group of 6th-graders?

The students from Fremont Elementary know when their hands are dirty. One student said he can see the dirt, "when I'm done playing basketball." Another said her hands get dirty because, "I like to play around a lot outside, play with my dog."
Just to make sure all the children had germs on their hands before we started, they rubbed them in their hair. It's a lab-approved way of collecting germs.
Then microbiologist Adrian Gallardo helped them press three dirty fingers into a Petri dish. Using a different brand on each child, we squirted a generous amount of sanitizer into their hands. The children thoroughly rubbed it in, and then they press their fingers in a different Petri dish.

Two days later, the results were in. "There is definitely variability between the products. And there's a wide span of range between the percentages that were killed." said Gallardo.
Before we get to those numbers, we found something about hand sanitizers the children didn't know and you might not, either. Some research suggests they should be used in addition to regular hand washing. In fact, the CDC says when your hands are visibly dirty, go for the soap and water. If you expect hand sanitizers to always kill all of the germs, you may be giving yourself a false sense of security.
With that in mind, two of the brands we tested did kill 99 percent of germs found on the children: Walgreen's and Delta hand sanitizers.
Five brands got rid of 90 percent to 98 percent of the germs. The brands were Family Dollar's store brand, Crystal Waters, Swan, germ-X and the American Red Cross sanitizer.
Next we tried Purell and Breck for Kids. In other tests around the country, both brands scored higher than our results, killing between 80 percent and 90 percent of the germs. Our Purell test came close to that at 79 percent.
The makers of Purell discounted our test saying our methods did not follow the Food and Drug Administration's (FDA) protocols and procedures. They said our results were not valid for scientific assessment. They stood by their promise to kill 99.99 percent of germs.
With Breck for Kids, our test killed just 16 percent of germs. One possible reason: the Petri dish shows the student who used this product started out with more germs than the other children. The company hasn't issued a response.
Finally, we tested two Bath & Body Works cleansers; the gel and the foam. The gel killed 98 percent of the bacteria. The foam was no match for the germs, killing just 8 percent of the germs. Bath and Body Works did not want to comment on our results. Data Chem lab suggests it could come down to different active ingredients. The gel is alcohol based, the foam is not.
E-mail: iteam@ksl.com








